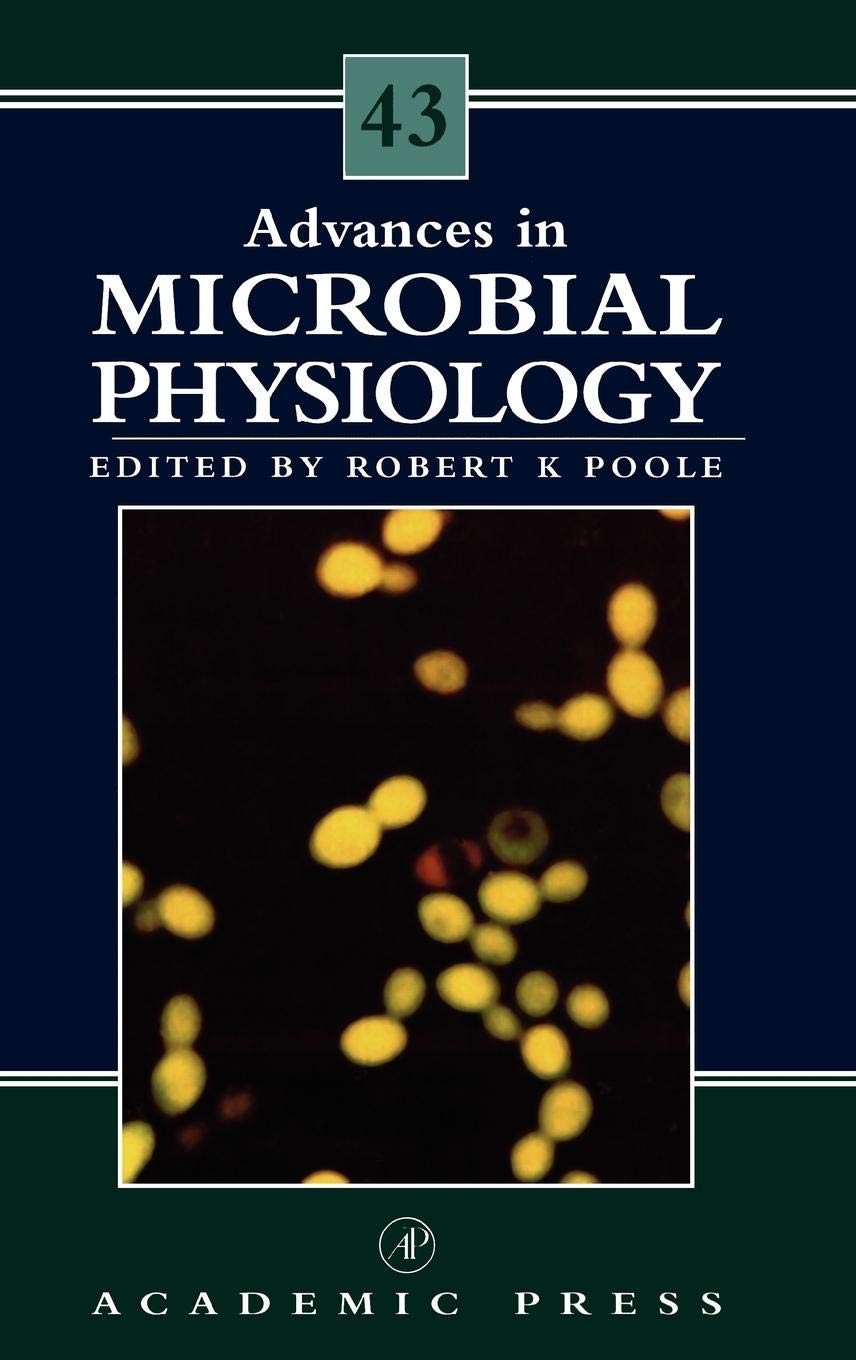

Title
Advances in Microbial Physiology (Volume 43),Used
Delivery time: 8-12 business days (International)
TOPICS COVERED IN THIS VOLUME1. The molecular genetics of cultivated mushrooms2. The intestinal microflora: potentially fertile ground for microbial physiologists3. Primary metabolism and its control in Streptomycetes: a most unusual group of bacteria4. Acid adaptation in oral Stretococci Covers recent advances in microscopical techniques Applicable to researchers in microscope instrumentation and to users in a range of disciplines, including biology, materials research and development, nondestructive testing, and the electronics service industry
By changing our most important processes and
products, we have already made a big leap forward. This ranges from the
increased use of more sustainable fibers to the use of more
environmentally friendly printing processes to the development of
efficient waste management in our value chain.
Shipping & Returns
Shipping
We ship your order within 2–3 business days for USA deliveries and 5–8 business days for international shipments. Once your package has been dispatched from our warehouse, you'll receive an email confirmation with a tracking number, allowing you to track the status of your delivery.
Returns
To facilitate a smooth return process, a Return Authorization (RA) Number is required for all returns. Returns without a valid RA number will be declined and may incur additional fees. You can request an RA number within 15 days of the original delivery date. For more details, please refer to our Return & Refund Policy page.
Shipping & Returns
Shipping
We ship your order within 2–3 business days for USA deliveries and 5–8 business days for international shipments. Once your package has been dispatched from our warehouse, you'll receive an email confirmation with a tracking number, allowing you to track the status of your delivery.
Returns
To facilitate a smooth return process, a Return Authorization (RA) Number is required for all returns. Returns without a valid RA number will be declined and may incur additional fees. You can request an RA number within 15 days of the original delivery date. For more details, please refer to our Return & Refund Policy page.
Warranty
We provide a 2-year limited warranty, from the date of purchase for all our products.
If you believe you have received a defective product, or are experiencing any problems with your product, please contact us.
This warranty strictly does not cover damages that arose from negligence, misuse, wear and tear, or not in accordance with product instructions (dropping the product, etc.).
Warranty
We provide a 2-year limited warranty, from the date of purchase for all our products.
If you believe you have received a defective product, or are experiencing any problems with your product, please contact us.
This warranty strictly does not cover damages that arose from negligence, misuse, wear and tear, or not in accordance with product instructions (dropping the product, etc.).
Secure Payment
Your payment information is processed securely. We do not store credit card details nor have access to your credit card information.
We accept payments with :
Visa, MasterCard, American Express, Paypal, Shopify Payments, Shop Pay and more.
Secure Payment
Your payment information is processed securely. We do not store credit card details nor have access to your credit card information.
We accept payments with :
Visa, MasterCard, American Express, Paypal, Shopify Payments, Shop Pay and more.